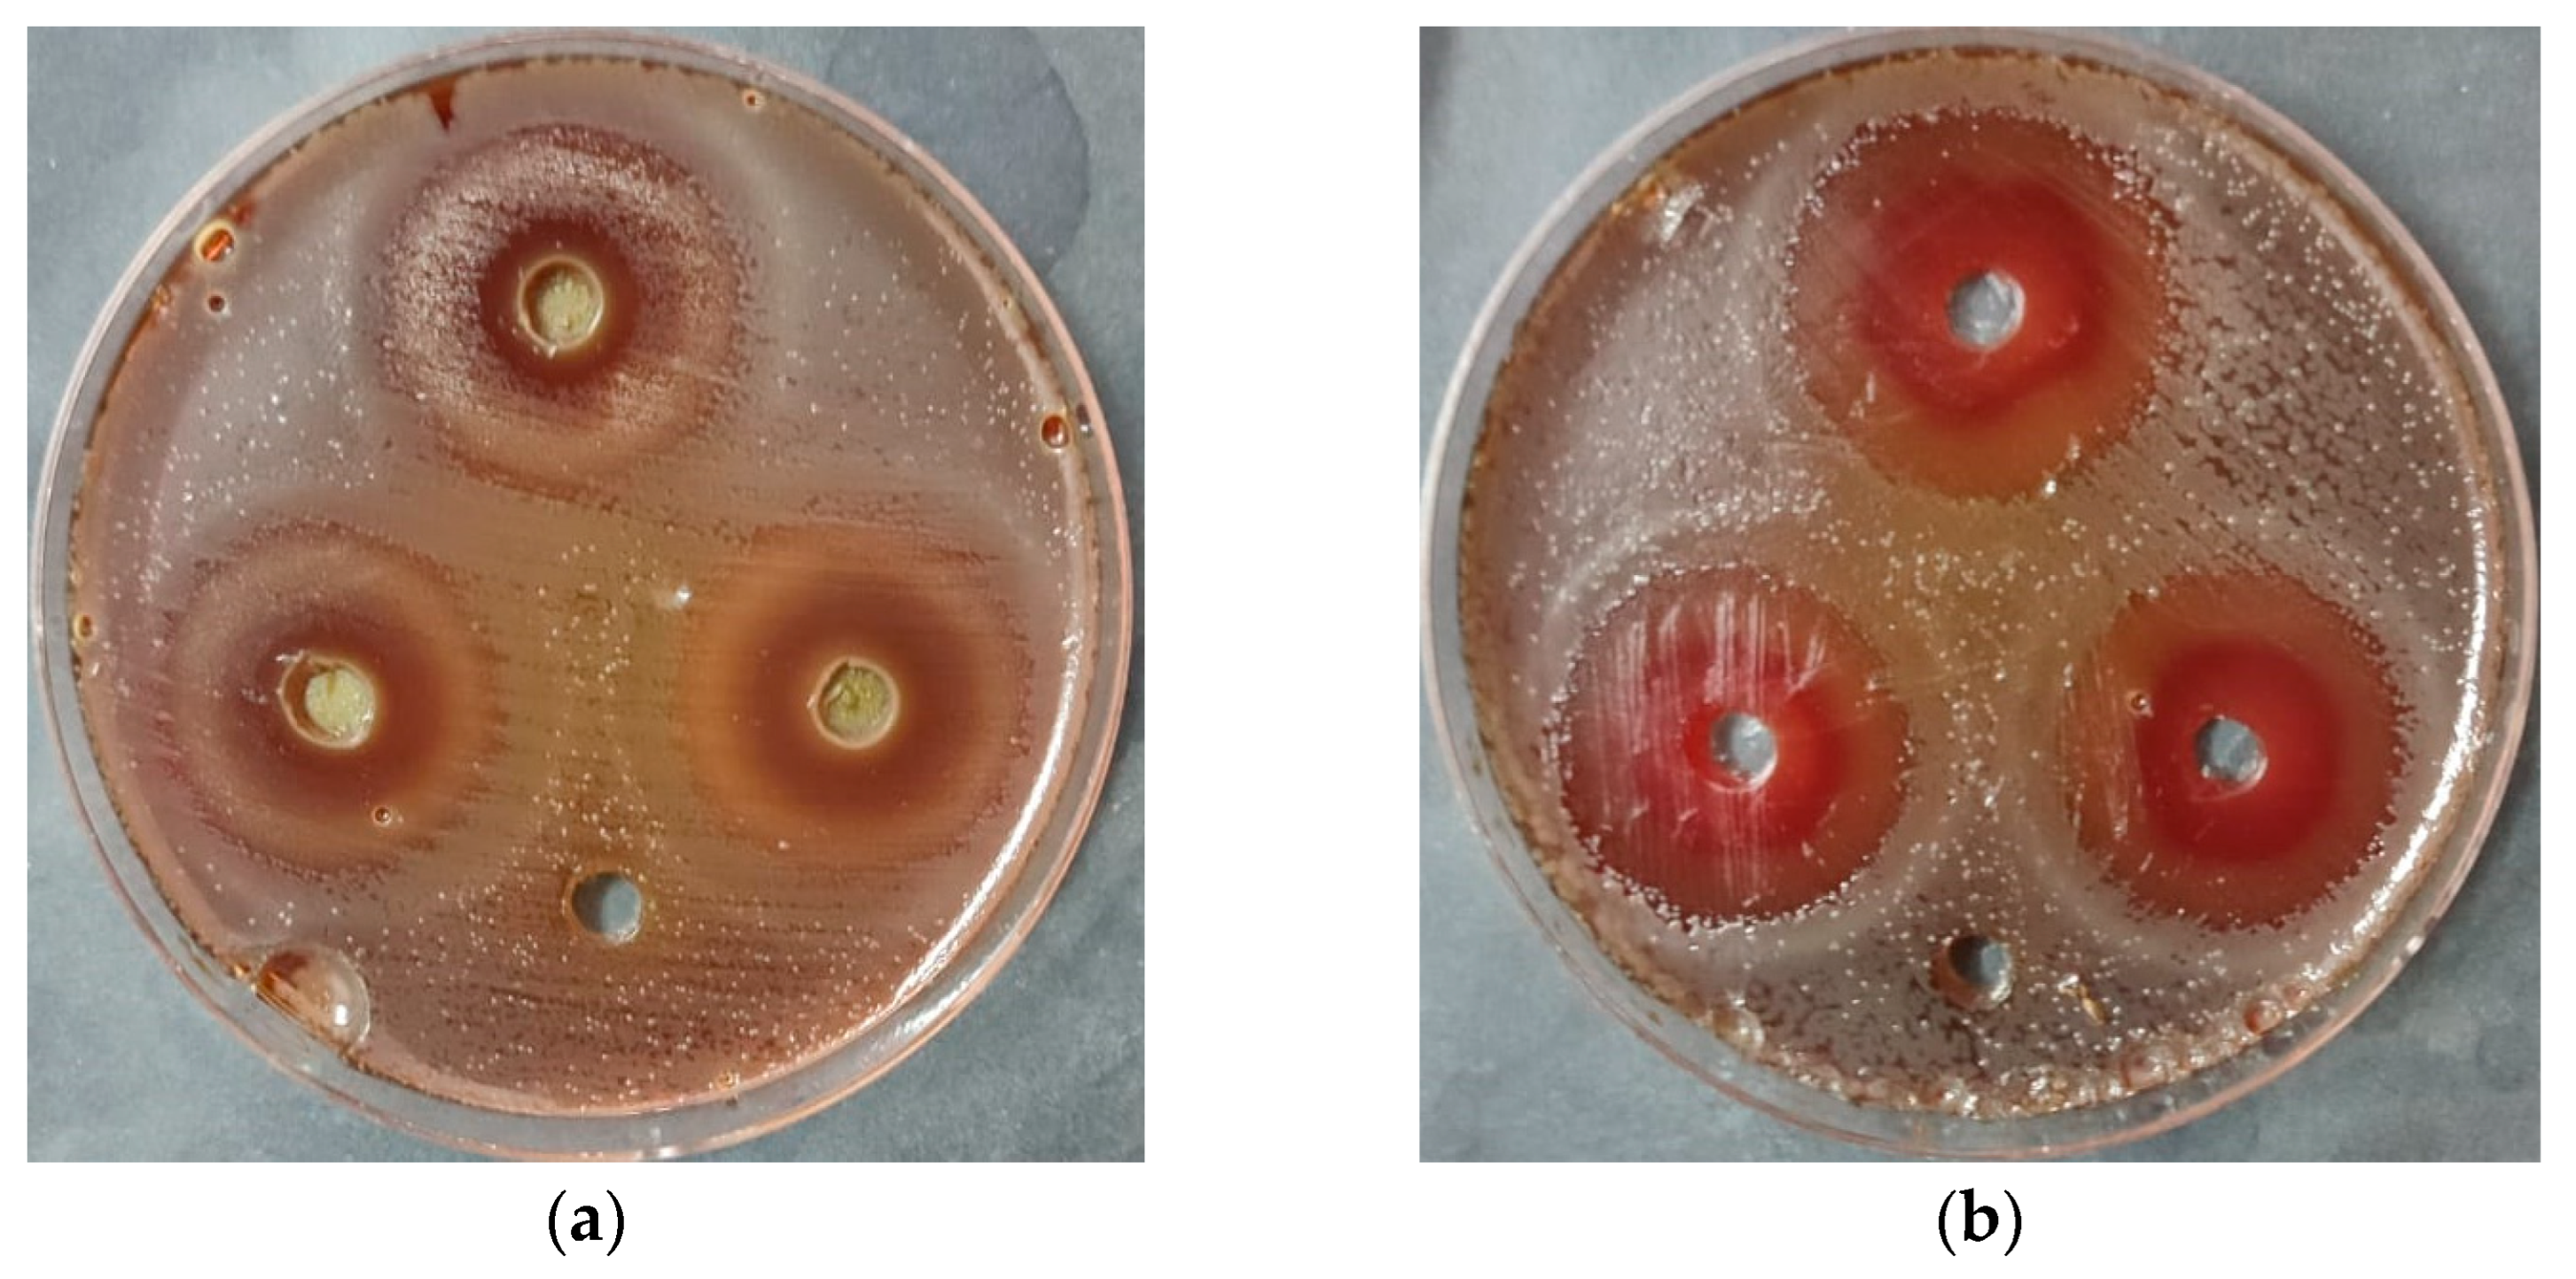

Therapeutic Potential of Ozonated Ocimum basilicum L. from Saudi Arabia: Phytochemical Characterization and Enhanced Bioactivities
Abstract
1. Introduction
2. Results and Discussion
2.1. Phytochemical Profiling of Non-Ozonated and Ozonated O. basilicum L. Extracts by HPLC
2.2. Antidiabetic Activity: Inhibition of α-Amylase and α-Glucosidase
2.3. Anti-Alzheimer Activity: Inhibition of Butyrylcholinesterase (BChE)
2.4. Anti-Inflammatory Activity: Inhibition of Hypotonic Red Blood Cell Hemolysis
2.5. Anti-Helicobacter pylori Activity
2.6. Determination of Minimum Inhibitory Concentration (MIC) and Minimum Bactericidal Concentration (MBC)
2.7. Cytotoxicity and Cell Viability in Normal Lung Fibroblasts (WI-38 Cell Line)
2.8. Cytotoxicity and Cell Viability in Colon Epithelial Cells (Caco-2 Cell Line)
3. Materials and Methods
3.1. Collection and Extraction of O. basilicum L.
3.2. HPLC Analysis
3.3. In Vitro α-Amylase Inhibition Assay
3.4. In Vitro α-Glucosidase Inhibition Assay
3.5. In Vitro Anti-Alzheimer Activity (Butyrylcholinesterase Inhibition)
3.6. In Vitro Anti-Inflammatory Activity (Hypotonic Hemolysis Method)
3.6.1. Preparation of Red Blood Cell (RBC) Suspension
3.6.2. Hypotonic Hemolysis Assay
3.7. The Determination of Anti-Helicobacter pylori Activity
3.7.1. Qualitative Agar Diffusion Assay
3.7.2. Quantitative Hemolysin Inhibition Assay
3.8. MIC and MBC Determination
3.9. Cytotoxicity Assay
3.10. Ozone Generation
3.11. Preparation of Resazurin Dye
3.12. Statistical Analysis
4. Conclusions
Author Contributions
Funding
Institutional Review Board Statement
Informed Consent Statement
Data Availability Statement
Acknowledgments
Conflicts of Interest
References
- Barickman, T.C.; Olorunwa, O.J.; Sehgal, A.; Walne, C.H.; Reddy, K.R.; Gao, W. Interactive Impacts of Temperature and Elevated CO2 on Basil (Ocimum basilicum L.) Root and Shoot Morphology and Growth. Horticulturae 2021, 7, 112. [Google Scholar] [CrossRef]
- Daniel, V.N.; Daniang, I.E.; Nimyel, N. Phytochemical analysis and mineral elements composition of Ocimum basilicum obtained in Jos Metropolis, Plateau State, Nigeria. Int. J. Eng. Technol. IJET-IJENS 2011, 11, 135–137. [Google Scholar]
- Khan Marwat, S.; Shoaib Khan, M.; Ghulam, S.; Anwar, N.; Mustafa, G.; Usman, K.; Rehman, F.-U. Phytochemical Constituents and Pharmacological Activities of Sweet Basil-Ocimum basilicum L. (Lamiaceae). Asian J. Chem. 2011, 23, 3773–3782. [Google Scholar]
- Taek, M.M.; Bambang, P.E.; Agil, M. Plants used in traditional medicine for treatment of malaria by Tetun ethnic people in West Timor Indonesia. Asian Pac. J. Trop. Med. 2018, 11, 630–637. [Google Scholar] [CrossRef]
- Silalahi, M.; Nisyawati; Walujo, E.B.; Supriatna, J.; Mangunwardoyo, W. The local knowledge of medicinal plants trader and diversity of medicinal plants in the Kabanjahe traditional market, North Sumatra, Indonesia. J. Ethnopharmacol. 2015, 175, 432–443. [Google Scholar] [CrossRef]
- Kasmawati, H.; Ruslin, I.S.; Yamin, M.D.; Elafita, W.O. Ethnomedicine studies of traditional medicinal plants of the Muna Tribe in the Village of Bungi Southeast Sulawesi Province of Indonesia. Int. J. Sci. Res. 2019, 8, 1882–1887. [Google Scholar]
- Aminian, A.R.; Mohebbati, R.; Boskabady, M.H. The Effect of Ocimum basilicum L. and Its Main Ingredients on Respiratory Disorders: An Experimental, Preclinical, and Clinical Review. Front. Pharmacol. 2021, 12, 805391. [Google Scholar] [CrossRef]
- Dhama, K.; Sharun, K.; Gugjoo, M.B.; Tiwari, R.; Alagawany, M.; Iqbal Yatoo, M.; Thakur, P.; Iqbal, H.M.N.; Chaicumpa, W.; Michalak, I.; et al. A Comprehensive Review on Chemical Profile and Pharmacological Activities of Ocimum basilicum. Food Rev. Int. 2023, 39, 119–147. [Google Scholar] [CrossRef]
- Abd El-Hamid, M.I.; El-Tarabili, R.M.; Bahnass, M.M.; Alshahrani, M.A.; Saif, A.; Alwutayd, K.M.; Safhi, F.A.; Mansour, A.T.; Alblwi, N.A.N.; Ghoneim, M.M.; et al. Partnering essential oils with antibiotics: Proven therapies against bovine Staphylococcus aureus mastitis. Front. Cell Infect. Microbiol. 2023, 13, 1265027. [Google Scholar] [CrossRef]
- Maneenoon, K.; Khuniad, C.; Teanuan, Y.; Saedan, N.; Prom-in, S.; Rukleng, N.; Kongpool, W.; Pinsook, P.; Wongwiwat, W. Ethnomedicinal plants used by traditional healers in Phatthalung Province, Peninsular Thailand. J. Ethnobiol. Ethnomed. 2015, 11, 43. [Google Scholar] [CrossRef] [PubMed]
- Montero, J.; Geducos, D. Ethnomedicinal plants used by the local folks in two selected villages of San Miguel, Surigao del Sur, Mindanao, Philippines. Int. J. Agric. Technol. 2021, 17, 193–212. [Google Scholar]
- Hadanu, R.; Kolaka, N.; Syahruddin, I.; Wahyuningrum, R.; Saparuddin, M.; Syahruddin, R.; Wahyuningrum, R.; Sartika, G.P. Ethnopharmacological survey of medicinal herbs in Tolaki-Mekongga Tribe of Kolaka Regency and East Kolaka Regency, Southeast Sulawesi, Indonesia. J. Med. Plants Stud. 2022, 10, 20–29. [Google Scholar] [CrossRef]
- Kurnia, D.; Putri, S.A.; Tumilaar, S.G.; Zainuddin, A.; Dharsono, H.D.A.; Amin, M.F. In silico Study of Antiviral Activity of Polyphenol Compounds from Ocimum basilicum by Molecular Docking, ADMET, and Drug-Likeness Analysis. Adv. Appl. Bioinform. Chem. 2023, 16, 37–47. [Google Scholar] [CrossRef]
- Hu, Q.; Xiong, Y.; Zhu, G.H.; Zhang, Y.N.; Zhang, Y.W.; Huang, P.; Ge, G.B. The SARS-CoV-2 main protease (M(pro)): Structure, function, and emerging therapies for COVID-19. MedComm 2022, 3, e151. [Google Scholar] [CrossRef]
- Yadav, H.; Mahalvar, A.; Pradhan, M.; Yadav, K.; Kumar Sahu, K.; Yadav, R. Exploring the potential of phytochemicals and nanomaterial: A boon to antimicrobial treatment. Med. Drug Discov. 2023, 17, 100151. [Google Scholar] [CrossRef]
- Anwar, F.; Alkharfy, K.M.; Mehmood, T.; Bakht, M.A.; Najeeb ur, R. Variation in Chemical Composition and Effective Antibacterial Potential of Ocimum basilicum L. Essential Oil Harvested from Different Regions of Saudi Arabia. Pharm. Chem. J. 2021, 55, 187–193. [Google Scholar] [CrossRef]
- Hussain, A.I.; Anwar, F.; Hussain Sherazi, S.T.; Przybylski, R. Chemical composition, antioxidant and antimicrobial activities of basil (Ocimum basilicum) essential oils depends on seasonal variations. Food Chem. 2008, 108, 986–995. [Google Scholar] [CrossRef] [PubMed]
- Viebahn-Haensler, R.; León Fernández, O.S. Ozone in Medicine. The Low-Dose Ozone Concept and Its Basic Biochemical Mechanisms of Action in Chronic Inflammatory Diseases. Int. J. Mol. Sci. 2021, 22, 7890. [Google Scholar] [CrossRef]
- Lacruz, R.S.; Habelitz, S.; Wright, J.T.; Paine, M.L. Dental Enamel Formation and Implications for Oral Health and Disease. Physiol. Rev. 2017, 97, 939–993. [Google Scholar] [CrossRef] [PubMed]
- Matłok, N.; Piechowiak, T.; Zardzewiały, M.; Balawejder, M. Effect of Ozone Treatment on the Contents of Selected Bioactive Phytochemicals in Leaves of Alligator Plant Kalanchoe daigremontiana. Appl. Sci. 2022, 12, 8934. [Google Scholar] [CrossRef]
- Pistón, M.; Machado, I.; Rodríguez-Arce, E.; Dol, I. Development of an Ozone-Assisted Sample Preparation Method for the Determination of Cu and Zn in Rice Samples. J. Anal. Methods Chem. 2021, 2021, 5586227. [Google Scholar] [CrossRef]
- Alsalamah, S.A.; Alghonaim, M.I.; Mohammad, A.M.; Khalel, A.F.; Alqahtani, F.S.; Abdelghany, T.M. Ozone-modified properties of pumpkin seed oil as anti-H. pylori, anticancer, anti-diabetic and anti-obesity agent. Sci. Rep. 2025, 15, 25959. [Google Scholar] [CrossRef] [PubMed]
- Pandey, A.; Tiwari, S.; Biswas, D.; Patel, Y.; Jajda, H.; Dave, G. Evaluation of Phytochemicals, Antioxidant and Anti-inflammatory properties of leaves of Ocimum basilicum L. Res. J. Pharm. Technol. 2023, 16, 1981–1986. [Google Scholar] [CrossRef]
- Güez, C.M.; Souza, R.O.d.; Fischer, P.; Leão, M.F.d.M.; Duarte, J.A.; Boligon, A.A.; Athayde, M.L.; Zuravski, L.; de Oliveira, L.F.S.; Machado, M.M. Evaluation of basil extract (Ocimum basilicum L.) on oxidative, anti-genotoxic and anti-inflammatory effects in human leukocytes cell cultures exposed to challenging agents. Braz. J. Pharm. Sci. 2017, 53, e15098. [Google Scholar] [CrossRef]
- Aburigal, Y.A.A.; Mirghani, M.E.S.; Elmogtaba, E.Y.; Sirible, A.A.; Hamza, N.; Hussein, I.H. Total phenolic content and antioxidant capacity of basil (Ocimum basilicum L.) leaves from different locations. Int. Food Res. J. 2017, 24, 378. [Google Scholar]
- Ezeani, C.; Ezenyi, I.; Okoye, T.; Okoli, C. Ocimum basilicum extract exhibits antidiabetic effects via inhibition of hepatic glucose mobilization and carbohydrate metabolizing enzymes. J. Intercult. Ethnopharmacol. 2017, 6, 22–28. [Google Scholar] [CrossRef]
- Shanak, S.; Bassalat, N.; Albzoor, R.; Kadan, S.; Zaid, H. In Vitro and In Silico Evaluation for the Inhibitory Action of O. basilicum Methanol Extract on α-Glucosidase and α-Amylase. Evid. Based Complement. Altern. Med. 2021, 2021, 5515775. [Google Scholar] [CrossRef] [PubMed]
- Moradabadi, L.; Montasser Kouhsari, S.; Fehresti Sani, M. Hypoglycemic Effects of Three Medicinal Plants in Experimental Diabetes: Inhibition of Rat Intestinal α-glucosidase and Enhanced Pancreatic Insulin and Cardiac Glut-4 mRNAs Expression. Iran. J. Pharm. Res. 2013, 12, 387–397. [Google Scholar]
- Mathews, S.; Nickles, M.; Williams, C.; Cantrell, C.; Mentreddy, S.R. Inhibition of Alpha-glucosidase Activity by Extracts of Ocimum Species (P06-040-19). Curr. Dev. Nutr. 2019, 3, nzz031.P006-040-019. [Google Scholar] [CrossRef]
- Mohammed, A.B.A.; Yagi, S.; Tzanova, T.; Schohn, H.; Abdelgadir, H.; Stefanucci, A.; Mollica, A.; Mahomoodally, M.F.; Adlan, T.A.; Zengin, G. Chemical profile, antiproliferative, antioxidant and enzyme inhibition activities of Ocimum basilicum L. and Pulicaria undulata (L.) C.A. Mey. grown in Sudan. S. Afr. J. Bot. 2020, 132, 403–409. [Google Scholar] [CrossRef]
- Al-Rajhi, A.M.H.; Qanash, H.; Almashjary, M.N.; Hazzazi, M.S.; Felemban, H.R.; Abdelghany, T.M. Anti-Helicobacter pylori, Antioxidant, Antidiabetic, and Anti-Alzheimer’s Activities of Laurel Leaf Extract Treated by Moist Heat and Molecular Docking of Its Flavonoid Constituent, Naringenin, against Acetylcholinesterase and Butyrylcholinesterase. Life 2023, 13, 1512. [Google Scholar] [CrossRef]
- Zhou, J.; Tang, Q.; Wu, T.; Cheng, Z. Improved TLC Bioautographic Assay for Qualitative and Quantitative Estimation of Tyrosinase Inhibitors in Natural Products. Phytochem. Anal. 2017, 28, 115–124. [Google Scholar] [CrossRef]
- Sudharshan, S.J.; Kekuda, T.R.P.; Sujatha, M.L. Antiinflammatory activity of Curcuma aromatica Salisb and Coscinium fenestratum Colebr: A comparative study. J. Pharm. Res. 2010, 3, 24–25. [Google Scholar]
- Fawole, O.A.; Ndhlala, A.R.; Amoo, S.O.; Finnie, J.F.; Van Staden, J. Anti-inflammatory and phytochemical properties of twelve medicinal plants used for treating gastro-intestinal ailments in South Africa. J. Ethnopharmacol. 2009, 123, 237–243. [Google Scholar] [CrossRef] [PubMed]
- Liu, C.; Dong, S.; Wang, X.; Xu, H.; Liu, C.; Yang, X.; Wu, S.; Jiang, X.; Kan, M.; Xu, C. Research progress of polyphenols in nanoformulations for antibacterial application. Mater. Today Bio 2023, 21, 100729. [Google Scholar] [CrossRef] [PubMed]
- Ivanov, M.; Kostić, M.; Stojković, D.; Soković, M. Rosmarinic acid–Modes of antimicrobial and antibiofilm activities of a common plant polyphenol. S. Afr. J. Bot. 2022, 146, 521–527. [Google Scholar] [CrossRef]
- Makarewicz, M.; Drożdż, I.; Tarko, T.; Duda-Chodak, A. The Interactions between Polyphenols and Microorganisms, Especially Gut Microbiota. Antioxidants 2021, 10, 188. [Google Scholar] [CrossRef]
- Lobiuc, A.; Pavăl, N.-E.; Mangalagiu, I.I.; Gheorghiță, R.; Teliban, G.-C.; Amăriucăi-Mantu, D.; Stoleru, V. Future Antimicrobials: Natural and Functionalized Phenolics. Molecules 2023, 28, 1114. [Google Scholar] [CrossRef]
- Baker, D.A. Plants against Helicobacter pylori to combat resistance: An ethnopharmacological review. Biotechnol. Rep. 2020, 26, e00470. [Google Scholar] [CrossRef]
- Soto, M.A.R.; Vázquez, C.A.R.; Chulia, N.W. Endoscopy evidence; H. Pylori infection Ozonetherapy treated, Mexican cases report. Ozone Ther. Glob. J. 2018, 8, 171–179. [Google Scholar]
- Haile, K.; Timerga, A. Evaluation of hematological parameters of Helicobacter pylori-infected adult patients at Southern Ethiopia: A comparative cross-sectional study. J. Blood Med. 2021, 12, 77–84. [Google Scholar] [CrossRef]
- Mwafy, S.N.; Afana, W.M. Hematological parameters, serum iron and vitamin B12 levels in hospitalized Palestinian adult patients infected with Helicobacter pylori: A case–control study. Hematol. Transfus. Cell Ther. 2018, 40, 160–165. [Google Scholar] [CrossRef]
- Ciacci, C.; Cavallaro, R.; Castiglione, F.; Di Bella, S.; Iovino, P.; Sabbatini, F.; Mellone, M.; Mazzacca, G. 17 P Helicobacter pylori impairs iron absorption in infected individuals. Dig. Liver Dis. 2002, 34, A15. [Google Scholar] [CrossRef]
- Jasem, M.A.; Al-Ubaidi, A.A.; Daood, N.M.; Muhsin, J.A. Iron deficiency in Helicobacter pylori infected patients in Baghdad. J. Microbiol. Infect. Dis. 2011, 1, 114–117. [Google Scholar] [CrossRef]
- Miguel, N. Hematological extradigestive manifestations of helicobacter pylori infection in childhood. In Extradigestive Manifestations of Helicobacter Pylori Infection—An Overview; Books on Demand: Norderstedt, Germany, 2016. [Google Scholar]
- Korona-Glowniak, I.; Glowniak-Lipa, A.; Ludwiczuk, A.; Baj, T.; Malm, A. The in vitro activity of essential oils against Helicobacter pylori growth and urease activity. Molecules 2020, 25, 586. [Google Scholar] [CrossRef]
- Governa, P.; Romagnoli, G.; Albanese, P.; Rossi, F.; Manetti, F.; Biagi, M. Effect of in vitro simulated digestion on the anti-Helicobacter Pylori activity of different Propolis extracts. J. Enzym. Inhib. Med. Chem. 2023, 38, 2183810. [Google Scholar] [CrossRef] [PubMed]
- Silvan, J.M.; Gutiérrez-Docio, A.; Moreno-Fernandez, S.; Alarcón-Cavero, T.; Prodanov, M.; Martinez-Rodriguez, A.J. Procyanidin-Rich Extract from Grape Seeds as a Putative Tool against Helicobacter pylori. Foods 2020, 9, 1370. [Google Scholar] [CrossRef] [PubMed]
- Naidu, J.R.; Gunjan, M.; Chen, Y.; Sasidharan, S. Evaluation of in vitro cytotoxic activity of Ocimum basilicum and Mentha spicata extracts. Asian J. Pharm. Clin. Res. 2016, 9, 131–134. [Google Scholar]
- Zarlaha, A.; Kourkoumelis, N.; Stanojkovic, T.; Kovala-Demertzi, D. Cytotoxic activity of essential oil and extracts of Ocimum basilicum against human carcinoma cells. Molecular docking study of isoeugenol as a potent cox and lox inhibitor. Dig. J. Nanomater. Biostruct. 2014, 9, 907–917. [Google Scholar]
- Hazekawa, M.; Nishinakagawa, T.; Kawakubo-Yasukochi, T.; Nakashima, M. Evaluation of IC(50) levels immediately after treatment with anticancer reagents using a real-time cell monitoring device. Exp. Ther. Med. 2019, 18, 3197–3205. [Google Scholar] [CrossRef]
- Berrouet, C.; Dorilas, N.; Rejniak, K.A.; Tuncer, N. Comparison of Drug Inhibitory Effects (IC50) in Monolayer and Spheroid Cultures. Bull. Math. Biol. 2020, 82, 68. [Google Scholar] [CrossRef]
- Verni, M.; Pontonio, E.; Krona, A.; Jacob, S.; Pinto, D.; Rinaldi, F.; Verardo, V.; Díaz-de-Cerio, E.; Coda, R.; Rizzello, C.G. Bioprocessing of Brewers’ Spent Grain Enhances Its Antioxidant Activity: Characterization of Phenolic Compounds and Bioactive Peptides. Front. Microbiol. 2020, 11, 1831. [Google Scholar] [CrossRef]
- Wickramaratne, M.N.; Punchihewa, J.C.; Wickramaratne, D.B.M. In-vitro alpha amylase inhibitory activity of the leaf extracts of Adenanthera pavonina. BMC Complement. Altern. Med. 2016, 16, 466. [Google Scholar] [CrossRef]
- Pistia-Brueggeman, G.; Hollingsworth, R.I. A preparation and screening strategy for glycosidase inhibitors. Tetrahedron 2001, 57, 8773–8778. [Google Scholar] [CrossRef]
- Ellman, G.L.; Courtney, K.D.; Andres, V.; Featherstone, R.M. A new and rapid colorimetric determination of acetylcholinesterase activity. Biochem. Pharmacol. 1961, 7, 88–95. [Google Scholar] [CrossRef]
- Gorun, V.; Proinov, I.; Baltescu, V.; Balaban, G.; Barzu, O. Modified Ellman procedure for assay of cholinesterases in crude enzymatic preparations. Anal. Biochem. 1978, 86, 324–326. [Google Scholar] [CrossRef] [PubMed]
- Sezgin, Z.; Biberoglu, K.; Chupakhin, V.; Makhaeva, G.F.; Tacal, O. Determination of binding points of methylene blue and cationic phenoxazine dyes on human butyrylcholinesterase. Arch. Biochem. Biophys. 2013, 532, 32–38. [Google Scholar] [CrossRef] [PubMed]
- Anosike, C.A.; Obidoa, O.; Ezeanyika, L.U. Membrane stabilization as a mechanism of the anti-inflammatory activity of methanol extract of garden egg (Solanum aethiopicum). DARU J. Pharm. Sci. 2012, 20, 76. [Google Scholar] [CrossRef]
- Shinde, U.A.; Phadke, A.S.; Nair, A.M.; Mungantiwar, A.A.; Dikshit, V.J.; Saraf, M.N. Membrane stabilizing activity—A possible mechanism of action for the anti-inflammatory activity of Cedrus deodara wood oil. Fitoterapia 1999, 70, 251–257. [Google Scholar] [CrossRef]
- Clinical & Laboratory Standards Institute. Performance Standards for Antimicrobial Susceptibility Testing. Available online: https://webstore.ansi.org/standards/clsi/clsim100s27?gad_source=1&gad_campaignid=22352210635&gbraid=0AAAAArA_aWZOtWeiZf1ldIE1N464q7Z-P&gclid=EAIaIQobChMIlNj-lbvajgMVR4KDBx2AXgz_EAAYASAAEgLd6vD_BwE (accessed on 15 February 2025).
- Qanash, H.; El-Fadl, S.R.A.; Binsaleh, N.K.; Aljahdali, I.A.; Altayar, M.A.; Khalel, A.F.; Alsalamah, S.A.; Alghonaim, M.I.; Abdelghany, T.M. Ecofriendly extraction approach of Moringa peregrina biomass and their biological activities in vitro. Biomass Convers. Biorefin. 2024, 15, 12205–12215. [Google Scholar] [CrossRef]
- Rossignol, G.; Merieau, A.; Guerillon, J.; Veron, W.; Lesouhaitier, O.; Feuilloley, M.G.J.; Orange, N. Involvement of a phospholipase C in the hemolytic activity of a clinical strain of Pseudomonas fluorescens. BMC Microbiol. 2008, 8, 189. [Google Scholar] [CrossRef]
- Malm, A.; Glowniak-Lipa, A.; Korona-Glowniak, I.; Baj, T. Anti-Helicobacter pylori activity in vitro of chamomile flowers, coneflower herbs, peppermint leaves and thyme herbs—A preliminary report. Curr. Issues Pharm. Med. Sci. 2015, 28, 30–32. [Google Scholar] [CrossRef]
- French, G.L. Bactericidal agents in the treatment of MRSA infections--the potential role of daptomycin. J. Antimicrob. Chemother. 2006, 58, 1107–1117. [Google Scholar] [CrossRef] [PubMed]
- Portugal, S.; Roy, S.; Lin, J. Functional relationship between material property, applied frequency and ozone generation for surface dielectric barrier discharges in atmospheric air. Sci. Rep. 2017, 7, 6388. [Google Scholar] [CrossRef] [PubMed]
- Choudhury, B.; Portugal, S.; Mastanaiah, N.; Johnson, J.A.; Roy, S. Inactivation of Pseudomonas aeruginosa and Methicillin-resistant Staphylococcus aureus in an open water system with ozone generated by a compact, atmospheric DBD plasma reactor. Sci. Rep. 2018, 8, 17573. [Google Scholar] [CrossRef] [PubMed]
- César, J.; Sumita, T.C.; Junqueira, J.C.; Jorge, A.O.; do Rego, M.A. Antimicrobial effects of ozonated water on the sanitization of dental instruments contaminated with E. coli, S. aureus, C. albicans, or the spores of B. atrophaeus. J. Infect. Public. Health 2012, 5, 269–274. [Google Scholar] [CrossRef]
- Morgan, N.N.; Elsabbagh, M.A.; Desoky, S.; Garamoon, A.A. Deactivation of yeast by dielectric barrier discharge. Eur. Phys. J. Appl. Phys. 2009, 46, 31001. [Google Scholar] [CrossRef]
- Gong, X.; Liang, Z.; Yang, Y.; Liu, H.; Ji, J.; Fan, Y. A resazurin-based, nondestructive assay for monitoring cell proliferation during a scaffold-based 3D culture process. Regen. Biomater. 2020, 7, 271–281. [Google Scholar] [CrossRef]

| Components | Standard | Non-Ozonated Saudi Basil | Ozonated Saudi Basil | |||
|---|---|---|---|---|---|---|
| Conc. (µg/mL) | Area | Conc. (µg/mL) | Area | Conc. (µg/mL) | Area | |
| Gallic acid | 20 | 248.33 | 727.67 a | 58.61 | 723.78 a | 58.29 |
| Chlorogenic acid | 50 | 391.71 | 382.63 a | 48.84 | 1207.83 b | 154.17 |
| Catechin | 75 | 329.15 | 0.00 a | 0.00 | 63.59 b | 14.49 |
| Methyl gallate | 15 | 291.59 | 125.02 a | 6.43 | 101.77 a | 5.24 |
| Caffeic acid | 18 | 220.63 | 288.91 a | 23.57 | 203.97 a | 16.64 |
| Syringic acid | 17.2 | 289.68 | 141.54 a | 8.40 | 179.96 a | 10.69 |
| Rutin | 50 | 410.85 | 65.71 a | 8.00 | 40.53 a | 4.93 |
| Ellagic acid | 70 | 568.31 | 115.05 a | 14.17 | 75.46 a | 9.30 |
| Coumaric acid | 20 | 600.85 | 122.46 a | 4.08 | 81.18 a | 2.70 |
| Vanillin | 12.9 | 350.04 | 769.67 a | 28.36 | 473.89 a | 17.46 |
| Ferulic acid | 20 | 357.33 | 625.38 a | 35.00 | 415.99 a | 23.28 |
| Naringenin | 30 | 334.36 | 39.51 | 3.55 | 15.32 | 1.38 |
| Rosmarinic acid | 50 | 501.19 | 1604.89 a | 160.11 | 1015.34 a | 101.29 |
| Daidzein | 20 | 319.64 | 692.21 a | 43.31 | 408.94 a | 25.59 |
| Quercetin | 20 | 300.41 | 1590.07 a | 105.86 | 965.95 a | 64.31 |
| Cinnamic acid | 10 | 584.22 | 212.01 a | 3.63 | 131.64 a | 2.25 |
| Kaempferol | 20 | 279.09 | 810.83 a | 58.10 | 504.15 a | 36.13 |
| Hesperetin | 20 | 418.68 | 23.65 a | 1.13 | 15.19 a | 0.73 |
| Conc. (µg/mL) | Mean A540 | α-Amylase Inhibition (%) | SD | SE | ||||||||
|---|---|---|---|---|---|---|---|---|---|---|---|---|
| Acar | SB | OSB | Acar | SB | OSB | Acar | SB | OSB | Acar | SB | OSB | |
| 1000 | 0.053 | 0.093 | 0.072 | 95.8 | 92.5 | 94.2 | 0.002 | 0.004 | 0.003 | 0.001 | 0.001 | 0.001 |
| 500 | 0.092 | 0.136 | 0.101 | 92.6 | 89.1 | 91.9 | 0.004 | 0.003 | 0.002 | 0.001 | 0.001 | 0.001 |
| 250 | 0.127 | 0.196 | 0.146 | 89.8 | 84.3 | 88.3 | 0.004 | 0.003 | 0.002 | 0.001 | 0.001 | 0.000 |
| 125 | 0.153 | 0.282 | 0.177 | 87.7 | 77.4 | 85.8 | 0.003 | 0.003 | 0.006 | 0.001 | 0.001 | 0.002 |
| 62.5 | 0.237 | 0.392 | 0.266 | 81.0 | 68.5 | 78.7 | 0.004 | 0.004 | 0.004 | 0.001 | 0.001 | 0.001 |
| 31.25 | 0.323 | 0.480 | 0.359 | 74.1 | 61.5 | 71.2 | 0.003 | 0.003 | 0.007 | 0.001 | 0.001 | 0.002 |
| 15.62 | 0.419 | 0.589 | 0.487 | 66.4 | 52.7 | 60.9 | 0.007 | 0.003 | 0.014 | 0.002 | 0.001 | 0.005 |
| 7.81 | 0.522 | 0.708 | 0.581 | 58.1 | 43.2 | 53.4 | 0.005 | 0.006 | 0.009 | 0.001 | 0.002 | 0.003 |
| 3.9 | 0.615 | 0.816 | 0.678 | 50.7 | 34.5 | 45.7 | 0.003 | 0.003 | 0.003 | 0.001 | 0.001 | 0.001 |
| 1.95 | 0.782 | 0.918 | 0.786 | 37.3 | 26.4 | 36.9 | 0.003 | 0.003 | 0.002 | 0.001 | 0.001 | 0.001 |
| 100% | 1.247 | 1.247 | 1.247 | 0.00 | 0.00 | 0.00 | 0.003 | 0.003 | 0.003 | 0.001 | 0.001 | 0.001 |
| IC50 | 3.47 a | 13.6 b | 5.09 a | |||||||||
| Conc. (µg/mL) | Mean A540 | α-Glucosidase Inhibition (%) | SD | SE | ||||||||
|---|---|---|---|---|---|---|---|---|---|---|---|---|
| Acar | SB | OSB | Acar | SB | OSB | Acar | SB | OSB | Acar | SB | OSB | |
| 1000 | 0.049 | 0.160 | 0.123 | 97.2 | 90.9 | 93.0 | 0.002 | 0.003 | 0.004 | 0.001 | 0.001 | 0.001 |
| 500.00 | 0.095 | 0.279 | 0.226 | 94.7 | 84.3 | 87.3 | 0.004 | 0.002 | 0.008 | 0.001 | 0.000 | 0.002 |
| 250.00 | 0.180 | 0.368 | 0.340 | 89.9 | 79.3 | 80.9 | 0.002 | 0.003 | 0.004 | 0.000 | 0.001 | 0.001 |
| 125.00 | 0.275 | 0.483 | 0.430 | 84.6 | 72.8 | 75.9 | 0.007 | 0.002 | 0.007 | 0.002 | 0.001 | 0.002 |
| 62.50 | 0.393 | 0.588 | 0.537 | 77.9 | 67.0 | 69.8 | 0.003 | 0.003 | 0.003 | 0.001 | 0.001 | 0.001 |
| 31.25 | 0.506 | 0.705 | 0.647 | 71.6 | 60.4 | 63.7 | 0.005 | 0.003 | 0.006 | 0.002 | 0.001 | 0.002 |
| 15.63 | 0.620 | 0.815 | 0.737 | 65.2 | 54.2 | 58.6 | 0.004 | 0.003 | 0.004 | 0.001 | 0.001 | 0.001 |
| 7.81 | 0.746 | 0.927 | 0.840 | 58.1 | 47.9 | 52.8 | 0.004 | 0.004 | 0.004 | 0.001 | 0.001 | 0.001 |
| 3.91 | 0.862 | 1.032 | 0.942 | 51.6 | 42.0 | 47.1 | 0.003 | 0.003 | 0.004 | 0.001 | 0.001 | 0.001 |
| 1.95 | 0.973 | 1.126 | 1.096 | 45.3 | 36.7 | 38.4 | 0.005 | 0.004 | 0.008 | 0.002 | 0.001 | 0.003 |
| Control | 1.745 | 1.745 | 1.745 | 0.00 | 0.00 | 0.00 | 0.006 | 0.006 | 0.006 | 0.002 | 0.002 | 0.002 |
| IC50 | 2.91 a | 9.42 b | 6.15 b | |||||||||
| Conc. (µg/mL) | Mean A405 | BChE Inhibition (%) | SD | SE | ||||||||
|---|---|---|---|---|---|---|---|---|---|---|---|---|
| RIV | SB | OSB | RIV | SB | OSB | RIV | SB | OSB | RIV | SB | OSB | |
| 100 | 0.009 | 0.080 | 0.053 | 95.6 | 62.1 | 74.8 | 0.001 | 0.001 | 0.001 | 0.000 | 0.000 | 0.000 |
| 50 | 0.020 | 0.096 | 0.068 | 90.5 | 54.4 | 67.8 | 0.001 | 0.001 | 0.001 | 0.000 | 0.000 | 0.000 |
| 25 | 0.028 | 0.107 | 0.101 | 86.7 | 49.4 | 52.0 | 0.001 | 0.001 | 0.001 | 0.000 | 0.000 | 0.000 |
| 12.5 | 0.044 | 0.118 | 0.111 | 79.2 | 44.3 | 47.6 | 0.002 | 0.002 | 0.002 | 0.000 | 0.000 | 0.000 |
| 6.25 | 0.054 | 0.145 | 0.124 | 74.4 | 31.4 | 41.2 | 0.002 | 0.002 | 0.002 | 0.000 | 0.000 | 0.000 |
| 3.125 | 0.070 | 0.158 | 0.138 | 66.9 | 25.2 | 34.8 | 0.002 | 0.002 | 0.002 | 0.001 | 0.001 | 0.001 |
| 1.56 | 0.081 | 0.181 | 0.159 | 61.7 | 14.5 | 24.8 | 0.004 | 0.004 | 0.004 | 0.001 | 0.001 | 0.001 |
| 0.78 | 0.093 | 0.193 | 0.175 | 55.8 | 8.7 | 17.2 | 0.002 | 0.002 | 0.002 | 0.001 | 0.001 | 0.001 |
| 0.39 | 0.108 | 0.200 | 0.188 | 48.9 | 5.3 | 11.0 | 0.003 | 0.003 | 0.003 | 0.001 | 0.001 | 0.001 |
| 0.195 | 0.127 | 0.201 | 0.197 | 39.9 | 4.9 | 6.6 | 0.003 | 0.003 | 0.003 | 0.001 | 0.001 | 0.001 |
| 0.000 | 0.2113 | 0.2113 | 0.2113 | 0.00 | 0.00 | 0.00 | 0.000 | 0.000 | 0.000 | 0.000 | 0.000 | 0.000 |
| IC50 | 0.46 a | 31.8 a | 13.4 c | |||||||||
| Conc. (µg/mL) | Mean A540 | Hemolysis Inhibition (%) | SD | SE | |||||||||||
|---|---|---|---|---|---|---|---|---|---|---|---|---|---|---|---|
| Hypotonic Sol. | Isotonic Sol. | ||||||||||||||
| IND | SB | OSB | IND | SB | OSB | IND | SB | OSB | IND | SB | OSB | IND | SB | OSB | |
| Control | 1.184 | 1.184 | 1.184 | 0.001 | 0.001 | 0.001 | 0.00 | 0.00 | 0.00 | 0.003 | 0.003 | 0.003 | 0.001 | 0.001 | 0.001 |
| 1000 | 0.035 | 0.062 | 0.055 | 0.021 | 0.021 | 0.021 | 98.8 | 96.5 | 97.0 | 0.003 | 0.005 | 0.005 | 0.001 | 0.001 | 0.002 |
| 500 | 0.083 | 0.102 | 0.094 | 0.015 | 0.015 | 0.015 | 94.2 | 92.6 | 93.2 | 0.002 | 0.003 | 0.002 | 0.001 | 0.001 | 0.001 |
| 250 | 0.104 | 0.141 | 0.138 | 0.011 | 0.011 | 0.011 | 92.0 | 88.9 | 89.2 | 0.003 | 0.008 | 0.005 | 0.001 | 0.003 | 0.001 |
| 125 | 0.181 | 0.215 | 0.207 | 0.009 | 0.009 | 0.009 | 85.4 | 82.4 | 83.1 | 0.005 | 0.003 | 0.005 | 0.002 | 0.001 | 0.001 |
| 62.5 | 0.262 | 0.292 | 0.288 | 0.005 | 0.005 | 0.005 | 78.2 | 75.6 | 76.0 | 0.006 | 0.003 | 0.003 | 0.002 | 0.001 | 0.001 |
| 31.25 | 0.345 | 0.396 | 0.391 | 0.003 | 0.003 | 0.003 | 71.0 | 66.8 | 67.2 | 0.003 | 0.004 | 0.003 | 0.001 | 0.001 | 0.001 |
| 15.62 | 0.449 | 0.507 | 0.502 | 0.002 | 0.002 | 0.002 | 62.2 | 57.2 | 57.7 | 0.007 | 0.003 | 0.005 | 0.002 | 0.001 | 0.001 |
| 7.8 | 0.562 | 0.626 | 0.621 | 0.001 | 0.001 | 0.001 | 52.6 | 47.1 | 47.6 | 0.003 | 0.003 | 0.002 | 0.001 | 0.001 | 0.001 |
| 3.9 | 0.623 | 0.737 | 0.728 | 0.001 | 0.001 | 0.001 | 47.4 | 37.8 | 38.5 | 0.004 | 0.004 | 0.001 | 0.001 | 0.001 | 0.000 |
| IC50 | 4.41 a | 8.44 b | 8.04 b | ||||||||||||
| Substance | Anti-Helicobacter pylori Activity (mm) | SD | SE | |||
|---|---|---|---|---|---|---|
| R 1 | R 2 | R 3 | Mean | |||
| Omeclamox-Pak (control) | 24 | 25 | 24 | 24.5 | 0.577 | 0.190 |
| Non-ozonated Saudi basil | 19 | 18 | 19 | 18.7 | 0.577 | 0.188 |
| Ozonated Saudi basil | 26 | 27 | 27 | 26.7 | 0.577 | 0.188 |
| Sample | A540 of Sample with RBCs | A540 of Sample with Isotonic Solution | Hemolysis (%) | SD | SE | |||||
|---|---|---|---|---|---|---|---|---|---|---|
| SB | OSB | SB | OSB | SB | OSB | SB | OSB | SB | OSB | |
| Control | 1.735 | 1.735 | 0.0001 | 0.0001 | 100 | 100 | 0.011 | 0.011 | 0.004 | 0.004 |
| (25% MIC) | 0.417 | 0.212 | 0.008 | 0.007 | 23.6 a | 11.8 b | 0.006 | 0.003 | 0.002 | 0.001 |
| (50% MIC) | 0.108 | 0.106 | 0.004 | 0.003 | 6.0 a | 6.0 a | 0.002 | 0.006 | 0.001 | 0.002 |
| (75% MIC) | 0.059 | 0.042 | 0.000 | 0.000 | 3.4 a | 2.4 a | 0.004 | 0.003 | 0.001 | 0.001 |
| Sample | MIC (µg/mL) | MBC (µg/mL) | MBC/MIC Index (µg/mL) |
|---|---|---|---|
| Omeclamox-Pak (Control) | 31.25 | 62.5 | 2 * |
| Non-ozonated Saudi basil | 15.62 | 31.25 | 2 * |
| Ozonated Saudi basil | 31.25 | 31.25 | 1 * |
| Sample | Conc. (µg/mL) | Mean of A560 | Viability (%) | Toxicity (%) | SD | SE | IC50 (µg/mL) |
|---|---|---|---|---|---|---|---|
| WI-38 cell line | None | 0.719 | 100 | 0.00 | None | 0.001 | None |
| Non-ozonated Saudi basil | 1000 | 0.06 | 8.35 | 91.65 | 4.01 | 0.004 | 191.06 ± 4.01 a |
| 500 | 0.085 | 11.87 | 88.13 | 4.01 | 0.002 | ||
| 250 | 0.232 | 32.32 | 67.68 | 4.01 | 0.007 | ||
| 125 | 0.483 | 67.23 | 32.77 | 4.01 | 0.010 | ||
| 62.5 | 0.694 | 96.57 | 3.43 | 4.01 | 0.003 | ||
| 31.25 | 0.719 | 100.0 | 0.00 | 4.01 | 0.001 | ||
| Ozonated Saudi basil | 1000 | 0.035 | 4.96 | 95.04 | 4.84 | 0.002 | 437.89 ± 4.84 b |
| 500 | 0.275 | 38.2 | 61.75 | 4.84 | 0.005 | ||
| 250 | 0.643 | 89.5 | 10.52 | 4.84 | 0.005 | ||
| 125 | 0.705 | 98.05 | 1.947 | 4.84 | 0.003 | ||
| 62.5 | 0.718 | 99.9 | 0.092 | 4.84 | 0.0008 | ||
| 31.25 | 0.719 | 100 | 0.00 | 4.84 | 0.0005 |
| Sample | Conc. (µg/mL) | Mean of A560 | Viability (%) | Toxicity (%) | SD | SE | IC50 µg/mL |
|---|---|---|---|---|---|---|---|
| Caco-2 cell line | None | 0.665 | 100 | 0.00 | None | 0.003 | None |
| Non-ozonated Saudi basil | 1000 | 0.017 | 2.656 | 97.34 | 1.16 | 0.0003 | 103.70 ± 1.16 a |
| 500 | 0.018 | 2.756 | 97.24 | 1.16 | 0.0003 | ||
| 250 | 0.026 | 3.959 | 96.04 | 1.16 | 0.0035 | ||
| 125 | 0.250 | 37.64 | 62.35 | 1.16 | 0.0077 | ||
| 62.5 | 0.487 | 73.23 | 26.76 | 1.16 | 0.0066 | ||
| 31.25 | 0.650 | 97.74 | 2.255 | 1.16 | 0.0046 | ||
| Ozonated Saudi basil | 1000 | 0.018 | 2.757 | 97.24 | 0.82 | 0.0003 | 149.14 ± 0.8 a |
| 500 | 0.018 | 2.807 | 97.19 | 0.82 | 0.0008 | ||
| 250 | 0.020 | 3.057 | 96.94 | 0.82 | 0.0008 | ||
| 125 | 0.349 | 52.48 | 47.52 | 0.82 | 0.0040 | ||
| 62.5 | 0.662 | 99.55 | 0.451 | 0.82 | 0.0020 | ||
| 31.25 | 0.665 | 100 | 0.00 | 0.82 | 0.0015 |
Disclaimer/Publisher’s Note: The statements, opinions and data contained in all publications are solely those of the individual author(s) and contributor(s) and not of MDPI and/or the editor(s). MDPI and/or the editor(s) disclaim responsibility for any injury to people or property resulting from any ideas, methods, instructions or products referred to in the content. |
© 2025 by the authors. Licensee MDPI, Basel, Switzerland. This article is an open access article distributed under the terms and conditions of the Creative Commons Attribution (CC BY) license (https://creativecommons.org/licenses/by/4.0/).
Share and Cite
Qanash, H.; Alsalamah, S.A.; Bazaid, A.S.; Alghonaim, M.I.; Duhduh, A.; Hudani, I. Therapeutic Potential of Ozonated Ocimum basilicum L. from Saudi Arabia: Phytochemical Characterization and Enhanced Bioactivities. Pharmaceuticals 2025, 18, 1223. https://doi.org/10.3390/ph18081223
Qanash H, Alsalamah SA, Bazaid AS, Alghonaim MI, Duhduh A, Hudani I. Therapeutic Potential of Ozonated Ocimum basilicum L. from Saudi Arabia: Phytochemical Characterization and Enhanced Bioactivities. Pharmaceuticals. 2025; 18(8):1223. https://doi.org/10.3390/ph18081223
Chicago/Turabian StyleQanash, Husam, Sulaiman A. Alsalamah, Abdulrahman S. Bazaid, Mohammed Ibrahim Alghonaim, Amro Duhduh, and Ibtisam Hudani. 2025. "Therapeutic Potential of Ozonated Ocimum basilicum L. from Saudi Arabia: Phytochemical Characterization and Enhanced Bioactivities" Pharmaceuticals 18, no. 8: 1223. https://doi.org/10.3390/ph18081223
APA StyleQanash, H., Alsalamah, S. A., Bazaid, A. S., Alghonaim, M. I., Duhduh, A., & Hudani, I. (2025). Therapeutic Potential of Ozonated Ocimum basilicum L. from Saudi Arabia: Phytochemical Characterization and Enhanced Bioactivities. Pharmaceuticals, 18(8), 1223. https://doi.org/10.3390/ph18081223

